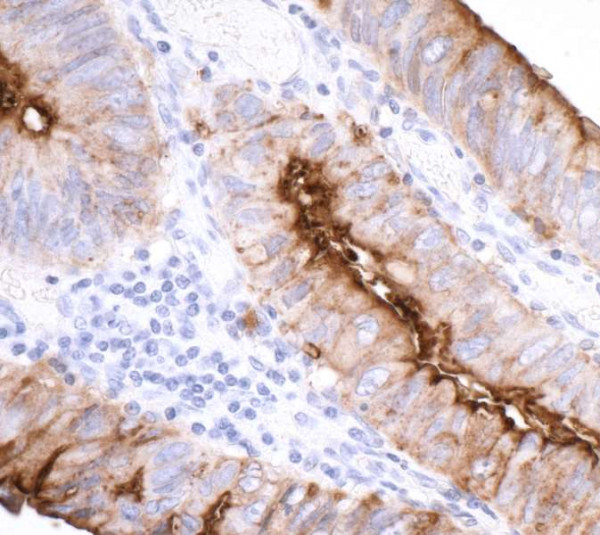
Anti-CEACAM1 Recombinant Monoclonal

Cookie preferences
This website uses cookies, which are necessary for the technical operation of the website and are always set. Other cookies, which increase the comfort when using this website, are used for direct advertising or to facilitate interaction with other websites and social networks, are only set with your consent.
Configuration
Technically required
These cookies are necessary for the basic functions of the shop.
"Allow all cookies" cookie
"Decline all cookies" cookie
CSRF token
Cookie preferences
Currency change
Customer-specific caching
FACT-Finder tracking
Individual prices
Selected shop
Session
Comfort functions
These cookies are used to make the shopping experience even more appealing, for example for the recognition of the visitor.
Note
Show the facebook fanpage in the right blod sidebar
Statistics & Tracking
Affiliate program
Conversion and usertracking via Google Tag Manager
Track device being used
| Item number | Size | Datasheet | Manual | SDS | Delivery time | Quantity | Price |
|---|---|---|---|---|---|---|---|
| A700-032-T | 10 µl (5+ tests) | - |
2 - 8 business days* |
172.00€
|
|||
| A700-032 | 100 µl (50+ tests) | - |
2 - 8 business days* |
652.00€
521.60€ |
If you have any questions, please use our Contact Form.
You can also order by e-mail: info@biomol.com
Larger quantity required? Request bulk
You can also order by e-mail: info@biomol.com
Larger quantity required? Request bulk
Protein function: Isoform 1: Cell adhesion protein that mediates homophilic cell adhesion in a... more
Product information "Anti-CEACAM1 Recombinant Monoclonal"
Protein function: Isoform 1: Cell adhesion protein that mediates homophilic cell adhesion in a calcium-independent manner. Plays a role as coinhibitory receptor in immune response, insulin action and functions also as an activator during angiogenesis (PubMed:18424730, PubMed:23696226, PubMed:25363763). Its coinhibitory receptor function is phosphorylation- and PTPN6 -dependent, which in turn, suppress signal transduction of associated receptors by dephosphorylation of their downstream effectors. Plays a role in immune response, of T cells, natural killer (NK) and neutrophils (PubMed:18424730, PubMed:23696226). Upon TCR/CD3 complex stimulation, inhibits TCR-mediated cytotoxicity by blocking granule exocytosis by mediating homophilic binding to adjacent cells, allowing interaction with and phosphorylation by LCK and interaction with the TCR/CD3 complex which recruits PTPN6 resulting in dephosphorylation of CD247 and ZAP70 (PubMed:18424730). Also inhibits T cell proliferation and cytokine production through inhibition of JNK cascade and plays a crucial role in regulating autoimmunity and anti-tumor immunity by inhibiting T cell through its interaction with HAVCR2 (PubMed:25363763). Upon natural killer (NK) cells activation, inhibit KLRK1-mediated cytolysis of CEACAM1-bearing tumor cells by trans-homophilic interactions with CEACAM1 on the target cell and lead to cis-interaction between CEACAM1 and KLRK1, allowing PTPN6 recruitment and then VAV1 dephosphorylation (PubMed:23696226). Upon neutrophils activation negatively regulates IL1B production by recruiting PTPN6 to a SYK-TLR4- CEACAM1 complex, that dephosphorylates SYK, reducing the production of reactive oxygen species (ROS) and lysosome disruption, which in turn, reduces the activity of the inflammasome. Downregulates neutrophil production by acting as a coinhibitory receptor for CSF3R by downregulating the CSF3R-STAT3 pathway through recruitment of PTPN6 that dephosphorylates CSF3R. Also regulates insulin action by promoting INS clearance and regulating lipogenesis in liver through regulating insulin signaling. Upon INS stimulation, undergoes phosphorylation by INSR leading to INS clearance by increasing receptor-mediated insulin endocytosis. This inernalization promotes interaction with FASN leading to receptor-mediated insulin degradation and to reduction of FASN activity leading to negative regulation of fatty acid synthesis. INSR-mediated phosphorylation also provokes a down-regulation of cell proliferation through SHC1 interaction resulting in decrease coupling of SHC1 to the MAPK3/ERK1-MAPK1/ERK2 and phosphatidylinositol 3-kinase pathways. Functions as activator in angiogenesis by promoting blood vessel remodeling through endothelial cell differentiation and migration and in arteriogenesis by increasing the number of collateral arteries and collateral vessel calibers after ischemia. Also regulates vascular permeability through the VEGFR2 signaling pathway resulting in control of nitric oxide production. Downregulates cell growth in response to EGF through its interaction with SHC1 that mediates interaction with EGFR resulting in decrease coupling of SHC1 to the MAPK3/ERK1-MAPK1/ERK2 pathway. Negatively regulates platelet aggregation by decreasing platelet adhesion on type I collagen through the GPVI-FcRgamma complex. Inhibits cell migration and cell scattering through interaction with FLNA, interfers with the interaction of FLNA with RALA (PubMed:16291724). Mediates bile acid transport activity in a phosphorylation dependent manner. Negatively regulates osteoclastogenesis. [The UniProt Consortium]
| Keywords: | Anti-CD66a, Anti-BGP-1, Anti-Biliary glycoprotein 1, Anti-Carcinoembryonic antigen-related cell adhesion molecule 1 |
| Supplier: | Bethyl Laboratories |
| Supplier-Nr: | A700-032 |
Properties
| Application: | WB, IP, IHC, ICC |
| Antibody Type: | Polyclonal |
| Conjugate: | No |
| Host: | Rabbit |
| Species reactivity: | human |
| Format: | Antigen Affinity Purified |
Database Information
| KEGG ID : | K06499 | Matching products |
| UniProt ID : | P13688 | Matching products |
| Gene ID : | GeneID 634 | Matching products |
Handling & Safety
| Storage: | +4°C |
| Shipping: | +4°C (International: +4°C) |
Caution
Our products are for laboratory research use only: Not for administration to humans!
Our products are for laboratory research use only: Not for administration to humans!
Information about the product reference will follow.
more
You will get a certificate here
Viewed